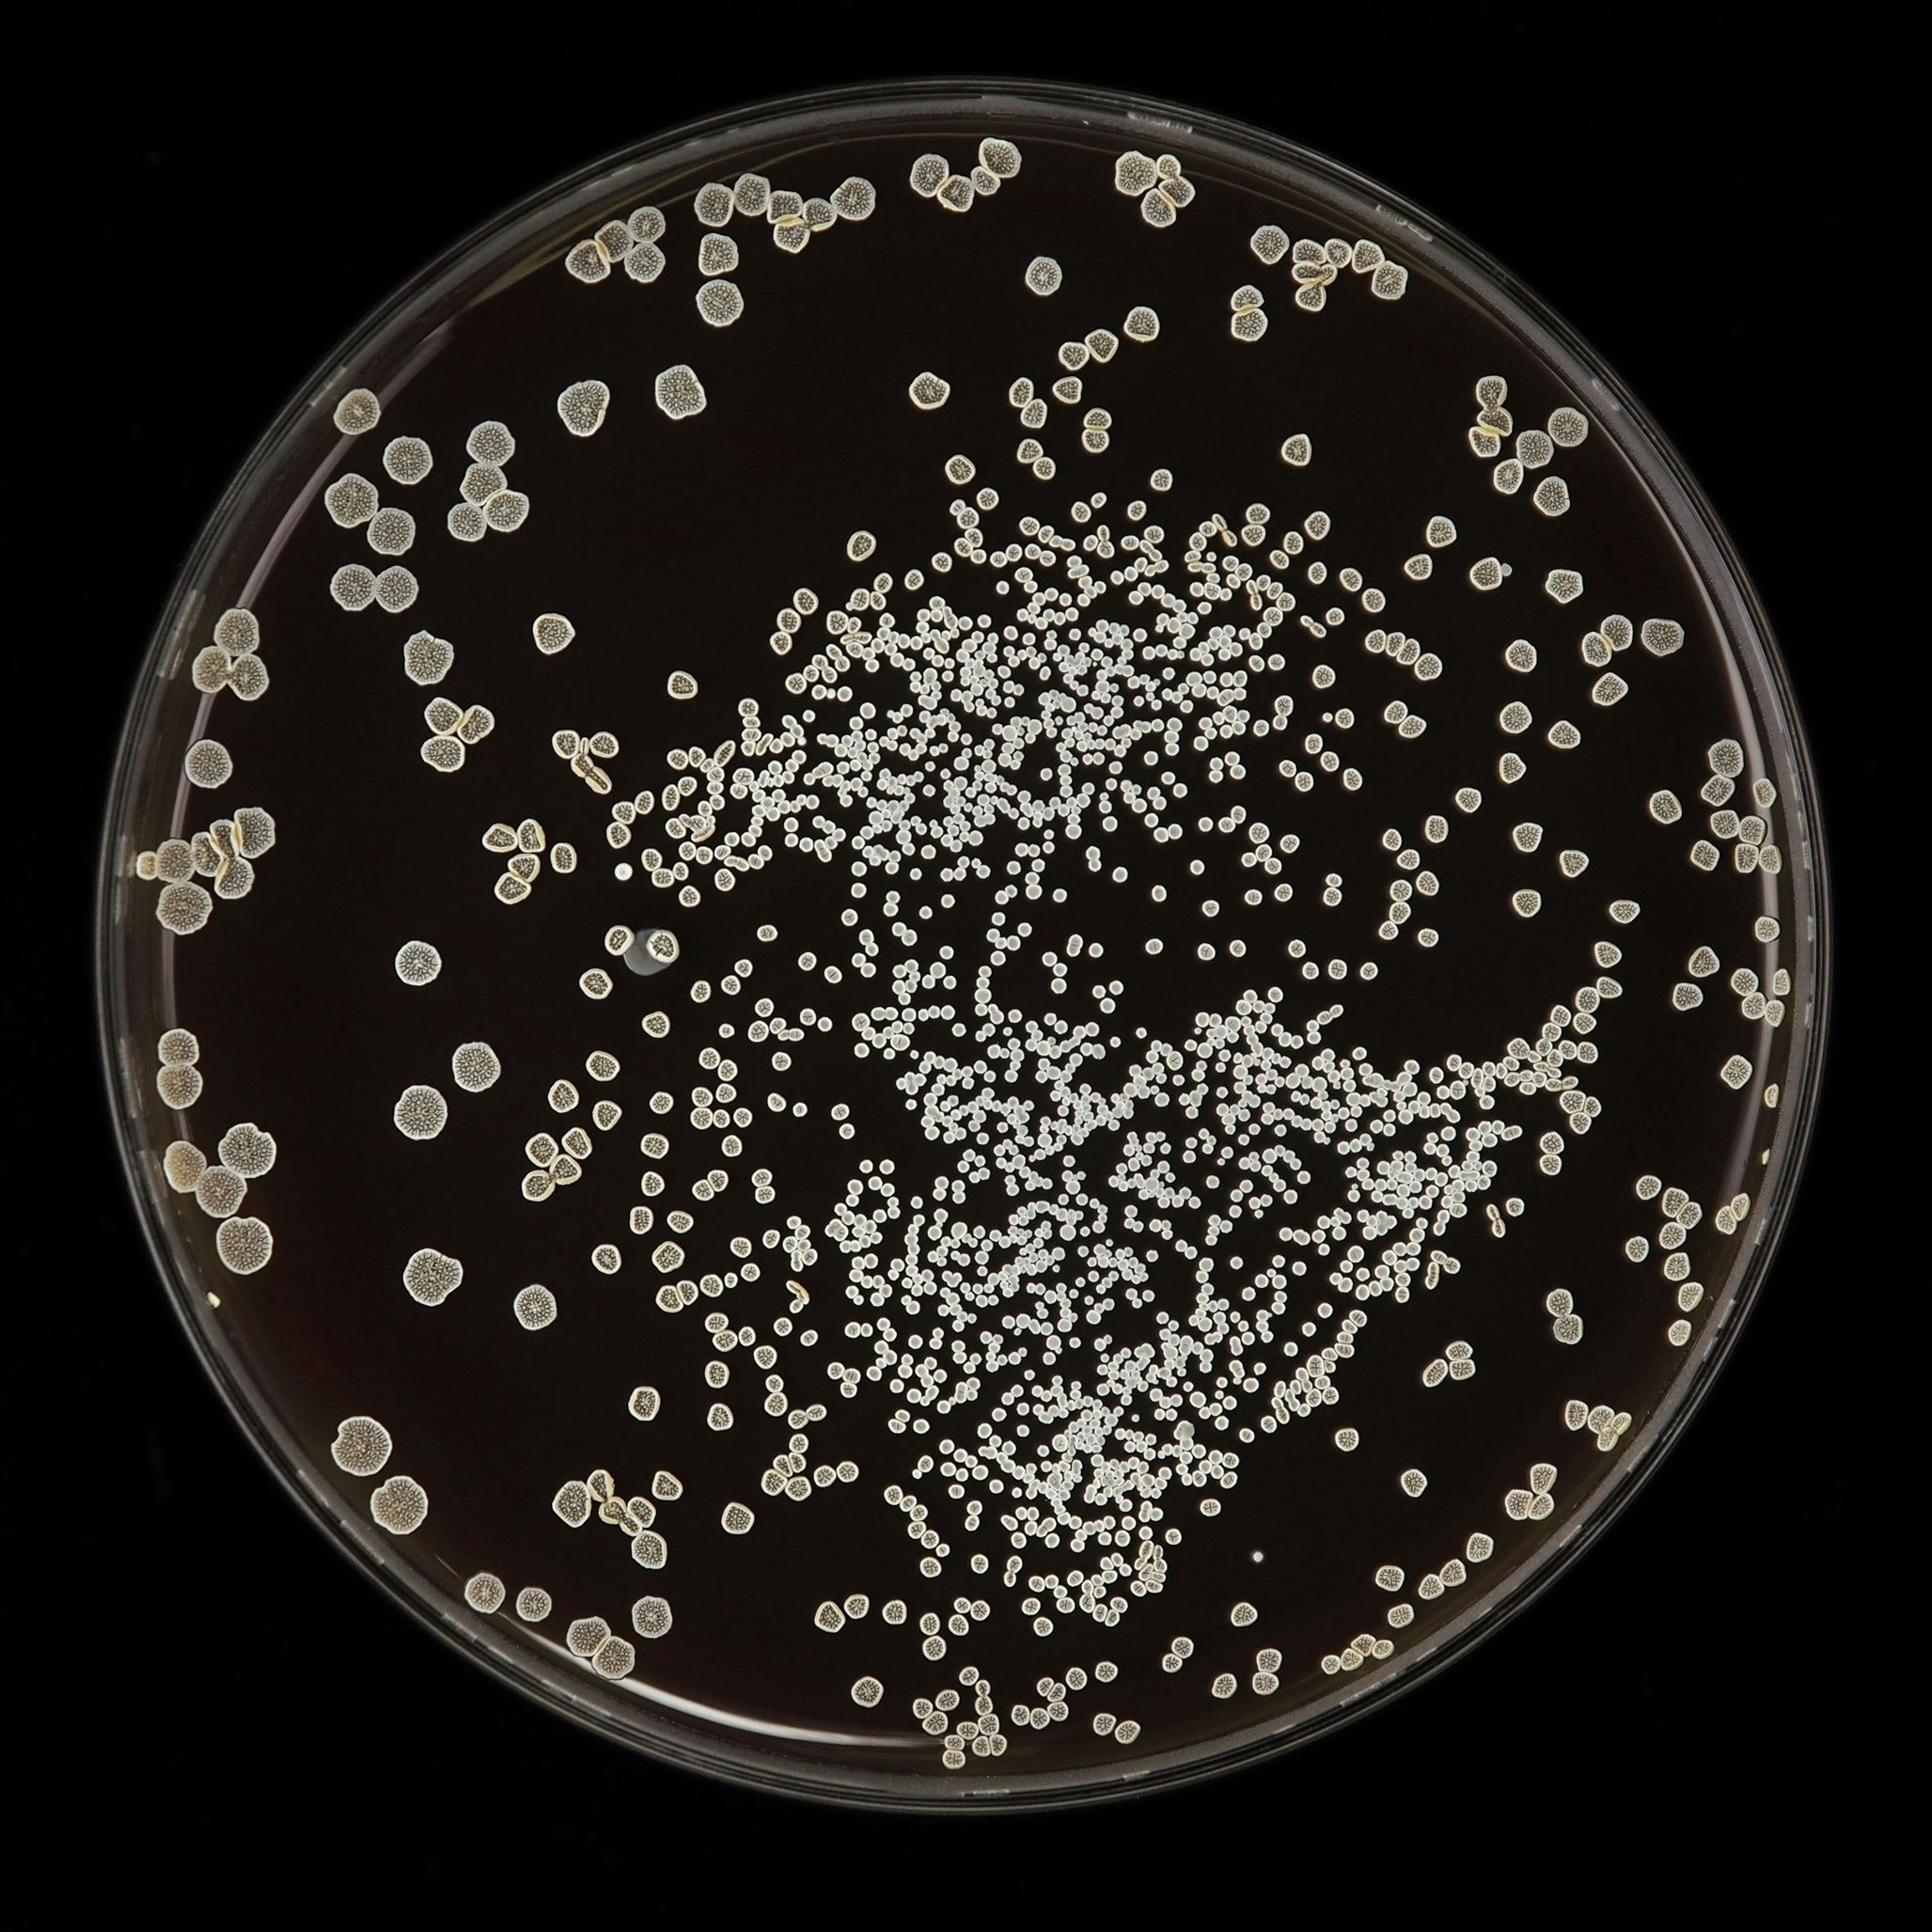

Maślan sodu

Szukając najskuteczniejszych rozwiązań dla zdrowia układu trawiennego, nie sposób pominąć maślanu sodu. To wyjątkowo stabilna forma kwasu masłowego, czyli kluczowego przedstawiciela krótkołańcuchowych kwasów tłuszczowych (SCFA).
W naturalnych warunkach powstaje on w naszym organizmie podczas bakteryjnej fermentacji błonnika, jednak jego niedobory są dziś powszechnym problemem.


KNOW-HOW
Strategiczne wsparcie bariery jelitowej

To nie jest po prostu kolejny dodatek do diety. Maślan sodu pełni rolę podstawowego źródła energii dla kolonocytów, czyli komórek tworzących nabłonek jelita grubego.
Jego obecność jest niezbędna do zachowania szczelności bariery jelitowej oraz wspierania procesów regeneracyjnych.
SAMO ZDROWIE
Kluczowe zalety maślanu sodu

Energia dla jelit: jest naturalnym „paliwem” dla komórek okrężnicy.
Zdrowy mikrobiom: maślan sodu wspiera rozwój pożytecznych bakterii.
Przeciwzapalny & innowacyjny: redukuje stany zapalne i wspiera zdrowie jelit, a także organizm w okresach zwiększonego obciążenia (np. stresem, antybiotykoterapią lub dietą ubogą w błonnik).

NASZA OFERTA
Formy dopasowane do potrzeb

Dostarczamy maślan sodu w formach, które pozwalają na precyzyjne dopasowanie surowca do finalnego przeznaczenia produktu:
Proszek – klasyczna baza do różnorodnych receptur
Granulat – ułatwiający procesy produkcyjne i dozowanie
Granulat o spowolnionym uwalnianiu – najbardziej zaawansowana forma, która gwarantuje, że substancja czynna dotrze do najdalszych odcinków jelit, nie ulegając zbyt wczesnemu rozkładowi
ZDROWIE + KOMFORT
Mamy wersje bezzapachowe!
Mamy wersje bezzapachowe!
W przypadku otoczkowanych maślanów od Bestpharma, innowacyjna technologia produkcji eliminuje nieprzyjemny zapach charakterystyczny dla kwasu masłowego.
Dzięki temu komfortowo dbasz o zdrowie każdego dnia!

WSPARCIE WDROŻENIA
Będziemy wsparciem na każdym etapie

Nieustannie śledzimy najnowsze trendy i potrzeby rynku, dzięki czemu jesteśmy w stanie dostosować ofertę do indywidualnych wymagań każdego klienta. Zapewniamy wsparcie na każdym etapie produkcji, od wyboru odpowiednich substancji pomocniczych, poprzez proces powlekania, aż po wyrób końcowy.
Z nami możesz być pewny, że Twoje produkty będą nie tylko skuteczne, ale także bezpieczne i spełniające najwyższe standardy jakości.
Potrzebujesz fachowej porady?
Skontaktuj się z naszym
Product Managerem
